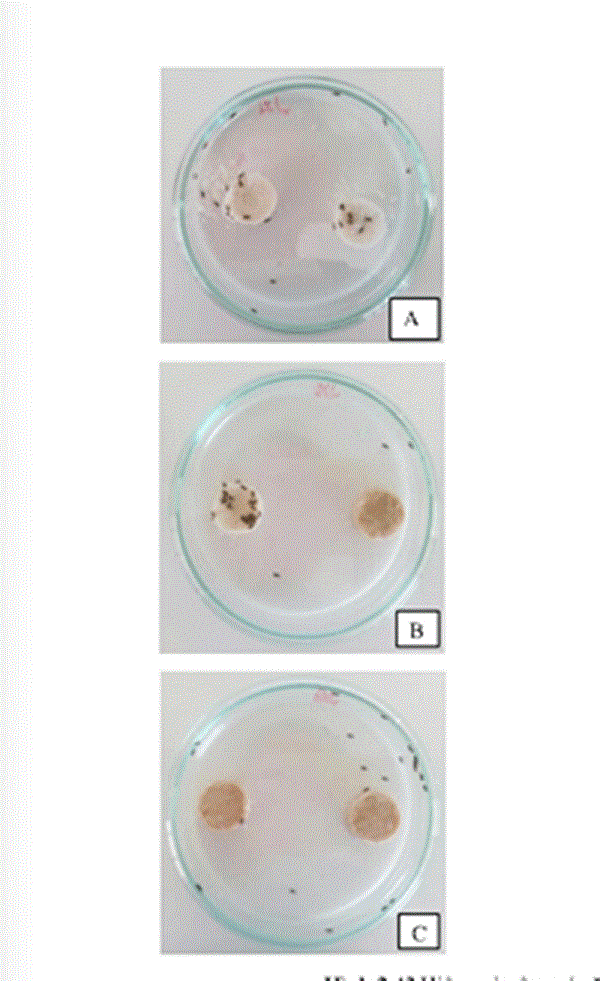

Chế phẩm thảo mộc phòng chống mọt gạo, thay thế chất bảo quản
Nhóm các nhà khoa học ở Viện Sinh học nhiệt đới đã nghiên cứu chế phẩm từ chitosan và dầu neem (xoan Ấn Độ) để phòng chống mọt gạo, có thể thay thế thuốc bảo quản lương thực bằng hóa học.

Chế phẩm dạng bột. Ảnh: Nhóm nghiên cứu
Theo TS. Nguyễn Thị Như Quỳnh, Chủ nhiệm đề tài nghiên cứu nói trên, đối với lương thực bảo quản ở trong kho, mọt gạo (Sitophilus oryzae) được xếp vào loại sâu hại số một, bởi mọt gạo ăn hại tất cả các loại lương thực, sinh sản rất nhanh, khả năng thích nghi rộng với các điều kiện ngoại cảnh khác nhau, thời gian sống dài hơn các loại mọt khác.
Có nhiều biện pháp khác nhau để phòng trừ côn trùng có hại trong kho bảo quản lương thực; trong đó, bcứu.iện pháp chủ yếu bao gồm cơ lý, hóa học, và sinh học. Biện pháp cơ lý dùng quạt, sàng, máy hút gió để loại bỏ sâu bọ và hạt ngũ cốc bị hại, thường áp dụng cho hạt giống và ngũ cốc có giá trị kinh tế cao. Biện pháp hóa học được sử dụng phổ biến hiện nay do thuận tiện, dễ áp dụng trên quy mô lớn, phổ tiêu diệt rộng. Tuy nhiên biện pháp này có nhược điểm lớn là độc tính cao, dễ cháy nổ, không đảm bảo an toàn cho người sử dụng.
Biện pháp sinh học phổ biến được nhiều nước áp dụng là dùng các loại thiên địch như ong, kiến, bọ cạp giả,.... hoặc các chế phẩm sinh học sử dụng các chủng vi khuẩn làm thuốc diệt côn trùng. Ngoài ra, các chế phẩm thảo mộc, được tách chiết từ thực vật để diệt trừ sâu bọ có hại, ít gây ô nhiễm môi trường, an toàn cho người sử dụng đang được quan tâm nghiên cứu.
Ở Việt Nam, biện pháp bảo quản kho bằng thảo mộc thường chỉ được áp dụng trong dân gian và nghiên cứu thử nghiệm trong phòng thí nghiệm, chưa có sản phẩm nào được sử dụng phổ biến, có hiệu quả, thay thế cho các loại thuốc hóa học độc hại.

Chế phẩm dạng dung dịch. Ảnh: Nhóm nghiên cứu
Dựa vào những đặc tính của cây neem có chứa các hoạt chất có khả năng phòng trừ dịch hại, gây ngán ăn, làm giảm sức sinh sản,… ở côn trùng, nhóm nghiên cứu đã chế tạo chế phẩm dạng lỏng vi nhũ tương bao gồm chitosan và dầu neem. Trong đó, hàm lượng dầu neem 43,48%, đạt TCVN 8383-2010, có khả năng huyền phù (hệ thống một chất lỏng và chất rắn phân tán trong chất lỏng nhưng không bị hòa tan) trong nước tốt, tạo điều kiện cho người sử dụng xử lý kho phun sương hoặc phun mù. Đồng thời, nhóm cũng chế tạo chế phẩm nói trên dạng bột, đựng trong các túi vải không dệt, có hàm lượng dầu neem 4% có thể phòng trừ mọt gạo bằng phương pháp xông hơi.
Sản phẩm đã được nhóm đánh giá thử nghiệm trên quy mô thí nghiệm, theo đó, mọt gạo không ăn mẫu bánh có tẩm chế phẩm nói trên. Đối với kho chứa nhỏ - 2,5kg/bao, 5kg/bao - lượng mọt gạo giảm hơn 90% so với đối chứng sau 12 tuần theo dõi. Khi sử dụng chế phẩm phun mù lên các bao gạo, kết quả cho thấy hư hại của gạo do mọt gây ra giảm khoảng 6,5 lần, giảm được sự hao hụt của khối lượng gạo gần 2% so với đối chứng.
Thí nghiệm mọt gạo không ăn ở mẫu bánh tẩm chế phẩm. Ảnh: Nhóm nghiên cứu
Nồng độ khuyến cáo được sử dụng là 4% hòa tan hoàn toàn phun mù lên các bao gạo. 1 lít chế phẩm có thể phun cho 1 tấn gạo. Đối với chế phẩm dạng bột, 1kg bột có thể dùng cho 1 tấn gạo, có tác dụng kéo dài 3 tháng.
Các chế phẩm cũng không gây độc và chết chuột khi được thí nghiệm (liều tối đa 30g/kg thể trọng chuột, gấp 6 lần so với chuẩn của Bộ Y tế cho phép).
Thời gian tới, nhóm tiếp tục đánh giá chỉ tiêu và phát triển sản phẩm để nâng cao hiệu quả xua đuổi, ngán ăn và thử nghiệm trên quy mô lớn hơn với một số đối tượng côn trùng hại kho khác. Đồng thời, khảo nghiệm chế phẩm để xin cấp phép lưu hành.
Kiều Anh
khoahocphattrien.vn (vtvanh)